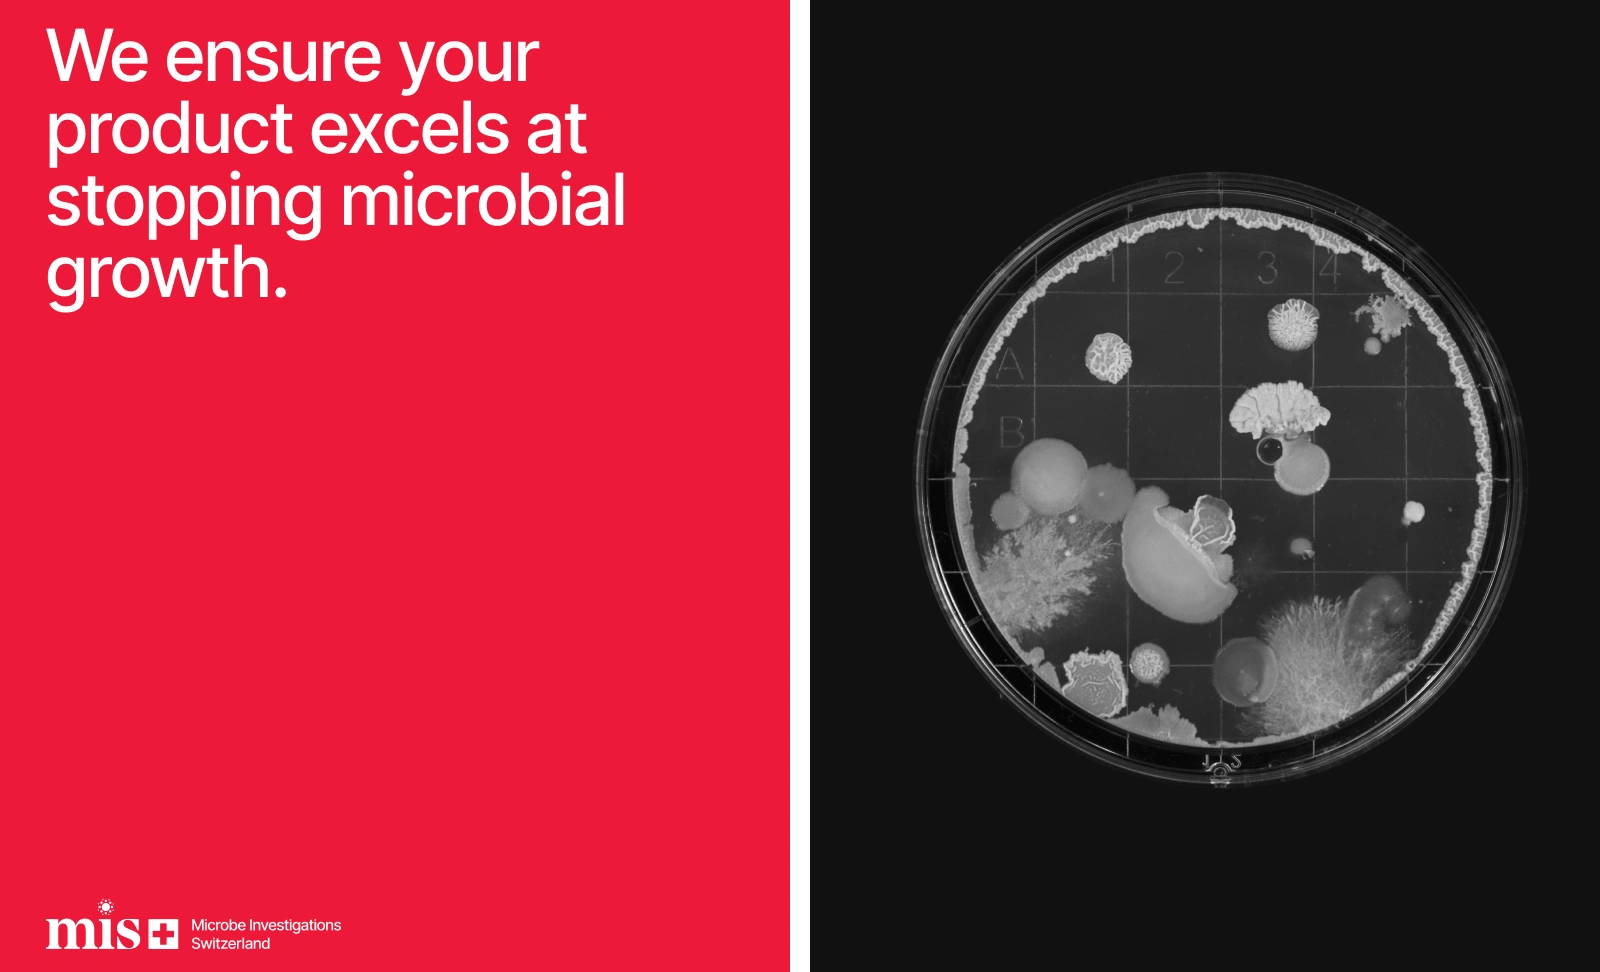

Microbe Investigations Switzerland (MIS)

Microbe Investigations Switzerland (MIS)
is a research-driven CRO that enables companies to validate their products' effectiveness with precision and confidence. Specializing in combating pests, bacteria, viruses, and fungi, we offer tailored R&D solutions that help clients across industries achieve reliable, science-backed results.
With our origins at the Swiss Federal Institute of Technology in Zürich, MIS delivers specialized expertise to support your product’s success from development to market. Whether you’re looking to enhance existing formulations or create innovative new solutions, our team provides the rigorous research and guidance needed to ensure your product stands out.
—
Project Scope: Strategy, Identity Design, UI/UX, Web Design, Web Development
Client: Microbe Investigations Switzerland (MIS)

Like this project
Posted Mar 20, 2026
Microbe Investigations Switzerland (MIS) is a research-driven CRO helping companies validate product effectiveness with scientific precision.



